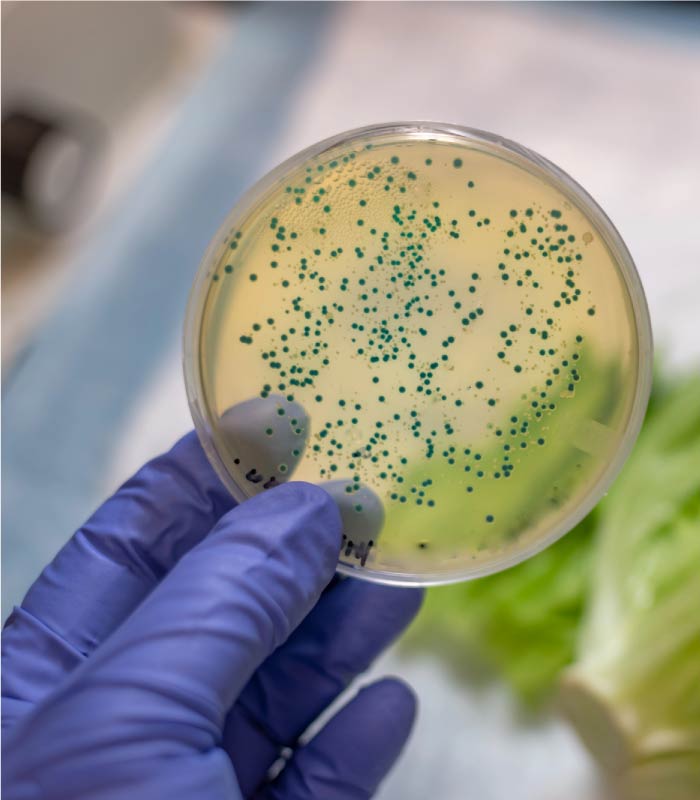
Listeria, Salmonella, and E. coli

Pathogen Control
Expert Pathogen Control and Monitoring
Foodborne pathogens are a serious concern in the food industry, and stringent controls are needed to maintain product safety. The presence of bacteria like Listeria, Salmonella, and E. coli poses a major threat to public health, brand reputation, and business continuity.
At Koenig Food Safety, LLC, we understand that a robust pathogen control program is the foundation of safe food production. We help you build a proactive, risk-based defense system to safeguard your facility and consumers.
Building a Robust Food Pathogen Control Program
A comprehensive food safety plan relies heavily on effectively monitoring and managing the risks posed by environmental pathogens. A strong program searches for pathogens such as Salmonella, E. coli, and Listeria.
Our experts specialize in developing tailored programs that meet your facility’s unique risk level, providing essential training and implementation support. We help you move beyond traditional food safety pillars like GMPs and HACCP by emphasizing a strong Environmental Monitoring of Pathogens (EMP) program.
Strategic Pathogen Monitoring and Environmental Testing
Identifying and controlling areas that support the survival and spread of pathogens is critical to maintaining a clean and hygienic food processing facility. Our approach is to help you locate and correct trouble spots before they become a crisis.
We can evaluate your existing testing program, facility design, and sanitation programs to offer valuable recommendations on improving your defense against these pathogens.
Key elements of our monitoring service include:
Environmental Pathogen Monitoring Program Design
We design a risk-based method to effectively monitor for and control environmental pathogens. This includes defining strategic test locations, frequency, and sample collection procedures.
Gap Assessments
We perform thorough audits to evaluate your current programs, focusing on identifying gaps in your GMPs, Sanitation Standard Operating Procedures, and hygienic design.
Preparation for Inspections
We ensure you are prepared in case of an FDA visit or a regulatory “swab-a-thon,” giving you peace of mind that your facility’s practices are defensible.
Mitigating Risk: Sanitation and Hygienic Design
Pathogen control is inseparable from a disciplined sanitation program and proper facility infrastructure. Listeria monocytogenes, for example, is notoriously hardy—it can survive and multiply even under refrigeration, making it a severe concern for ready-to-eat (RTE) foods.
Hygienic Facility Design to Prevent Pathogen Harborage
Controlling pathogens starts with the facility itself. We can provide guidance on building from the ground up or modifying an existing facility to improve sanitation and prevent cross-contamination.
Our expertise ensures that food safety is built into the process design, resulting in a facility that is efficient to clean, has hygienic traffic patterns, and improved sanitation. This is especially important for high-risk products like dairy and ready-to-eat foods.
Validated Control and Corrective Actions
Finding a pathogen in your facility’s environment must lead to swift and effective action. We help you establish a control plan for pathogens. Our team supports you in:
- Developing and implementing robust Prerequisite Programs that provide the environmental and operating conditions necessary for safe food production.
- Validation of your environmental pathogen monitoring program.
Frequently Asked Questions (FAQs)
Why are Listeria, Salmonella, and E. coli the main focus of pathogen monitoring?
These three pathogens are among the most common culprits of severe foodborne illnesses, which affect millions of people annually. They pose a risk to vulnerable populations (such as the elderly and those with weakened immune systems) and their persistence in food processing environments, often surviving for extended periods, makes their control a critical industry and regulatory focus.
What is Environmental Pathogen Monitoring, and how does it protect my brand?
Environmental Monitoring of Pathogens (EMP) is a risk-based control program that assesses your facility’s hygienic practices by searching for pathogens like Listeria on surfaces and in the environment. By catching contamination in the environment before it reaches the food, EMP is essential for preventing recalls, avoiding costly disruptions, and protecting your brand’s reputation.
Does Koenig Food Safety, LLC only work with large corporations on pathogen control?
No, our services are specially tailored to meet the needs of any company, no matter how small or large it may be. Whether you are a small start-up developing your first program or a large corporation seeking to improve existing controls, our consulting services are individually designed to improve your food safety measures.
How does Koenig Food Safety, LLC help with regulatory compliance for these pathogens?
Our experts provide guidance in meeting complex regulatory requirements, including adherence to mandates under FSMA (Food Safety Modernization Act). We can perform gap assessments on existing plans or build a complete plan from scratch to ensure full compliance with today’s complex food safety regulations.
Who at Koenig Food Safety, LLC is qualified to consult on pathogen control?
Our team is led by Beth Koenig, who is PCQI and HACCP certified and a trained SQF and BRCGS Practitioner. Her experience spans a wide variety of food sectors, including ready-to-eat products and dairy, giving her the expertise to handle stringent pathogen control requirements.
Secure Your Brand. Request a Pathogen Control Consultation Today.
Don’t wait for a regulatory inspection or a positive swab to expose critical gaps in your system. Food safety is the main ingredient for business success, and ensuring the safety of your food is our paramount concern.
Choose a trusted advisor who understands your unique challenges and can create a customized solution that ensures long-term success within the food chain.